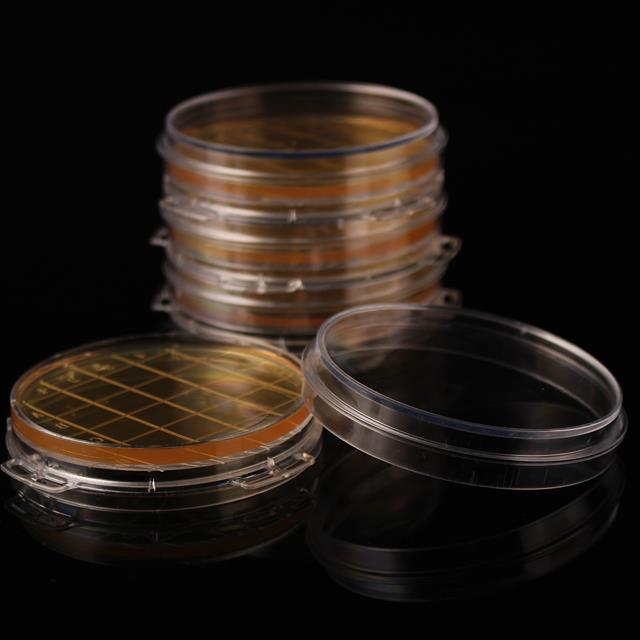
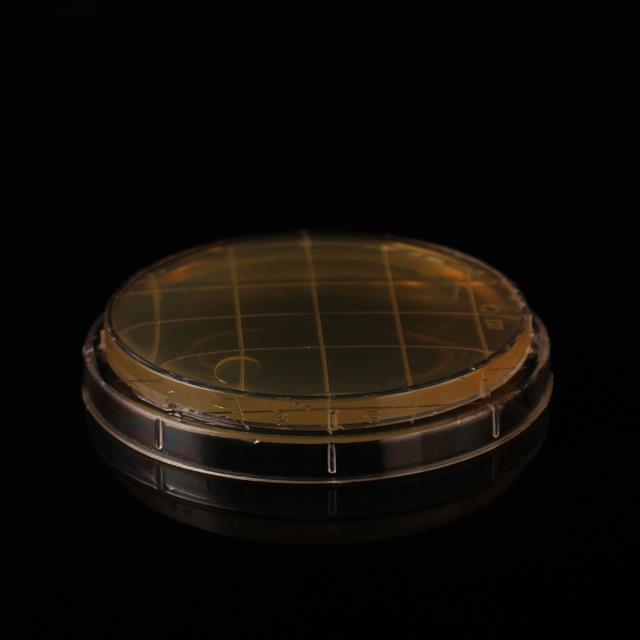
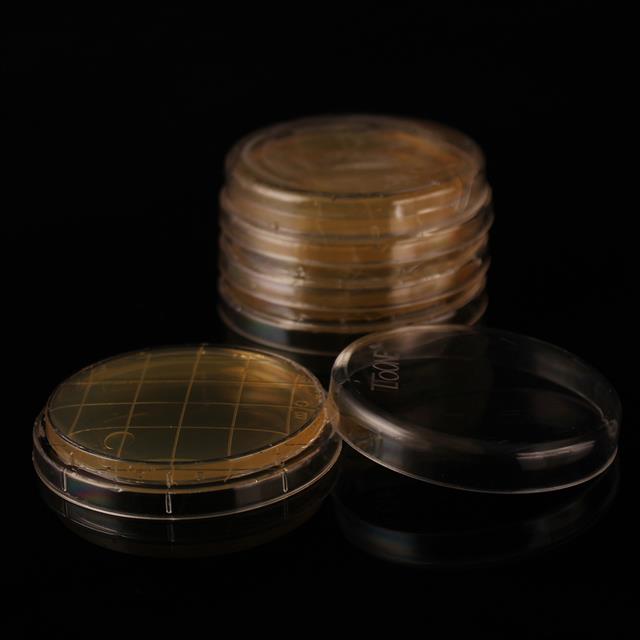

| Product No. | Product Name |
TW-90CY
Specifification
|
TW-75CY
Specifification
|
TW-55CY
Specifification
|
| 7001 | Tryptic Soy Agar Medium (TSA) | TW-TSA90CY | TW-TSA75CY | TW-TSA55CY |
| 7002 | Tryptic Soy Agar Medium (containing penicillinase) | TW-TSAQ90CY | TW-TSAQ75CY | TW-TSAQ55CY |
| 7003 | Tryptic Soy Agar Medium (containing cephalosporinase) | TW-TTSA90CY | TW-TTSA75CY | TW-TTSA55CY |
| 7004 | Plate Count Agar (PCA) | TW-PCA90CY | TW-PCA75CY | TW-PCA55CY |
| 7005 | Sabouraud Dextrose Agar Medium (SDA) | TW-SDA90CY | TW-SDA75CY | TW-SDA55CY |
| 7006 | Sabouraud Dextrose Agar Medium (containing chloramphenicol) | TW-SDAL90CY | TW-SDAL75CY | TW-SDAL55CY |
| 7007 | Rose Bengal Agar Medium (RA) | TW-RA90CY | TW-RA75CY | TW-RA55CY |
| 7008 | Rose Bengal Medium | TW-MJL90CY | TW-MJL75CY | TW-MJL55CY |
| 7009 | R2A Agar Medium | TW-R2A90CY | TW-R2A75CY | TW-R2A55CY |
| 7010 | Xylose Lysine Desoxycholate (XLD) Agar Medium | TW-XLD90CY | TW-XLD75CY | TW-XLD55CY |
| 7011 | Violet Red Bile Glucose Agar Medium (VRBGA) | TW-VRBGA90CY | TW-VRBGA75CY | TW-VRBGA55CY |
| 7012 | MacConkey (MAC) Agar | TW-MAC90CY | TW-MAC75CY | TW-MAC55CY |
| 7013 | Cetrimide Agar Medium (CA) | TW-CA90CY | TW-CA75CY | TW-CA55CY |
| 7014 | Mannitol and Sodium Chloride Agar Medium (MSA) | TW-MSA90CY | TW-MSA75CY | TW-MSA55CY |
| 7015 | Columbia Agar Medium | TW-GLBY90CY | TW-GLBY75CY | TW-GLBY55CY |
| 7016 | Candida Chromogenic Medium | TW-NZ90CY | TW-NZ75CY | TW-NZ55CY |
| 7017 | SS Agar | TW-SS90CY | TW-SS75CY | TW-SS55CY |
| 7018 | Violet Red Bile Agar (VRBA) | TW-VRBA90CY | TW-VRBA75CY | TW-VRBA55CY |
| 7019 | Violet Red Bile Dextrose Agar/Violet Red Bile Glucose Agar(VRBDA/VRBGA) | TW-VRBDA90CY | TW-VRBDA75CY | TW-VRBDA55CY |
| 7020 | Nutrient Agar | TW-NA90CY | TW-NA75CY | TW-NA55CY |
| 7021 | Hektoen Enteric Agar(HE) | TW-HE90CY | TW-HE75CY | TW-HE55CY |
| 7022 | Mannitol-Egg-Yolk-Polymyxin (MYP) Agar | TW-MYP90CY | TW-MYP75CY | TW-MYP55CY |
| 7023 | Enterobacter Sakazakii Chromogenic Medium | TW-BQC90CY | TW-BQC75CY | TW-BQC55CY |
| 7024 | Basal Layer Medium | TW-DC90CY | TW-DC75CY | TW-DC55CY |
| 7025 | TrypticSoy Agar Medium(containing Tween 80 and lecithin) | TW-TSA80R90CY | TW-TSA80R75CY | TW-TSA80R55CY |
| 7026 | Sabouraud Dextrose Agar Medium(containing gentamicin) | TW-SDAQ90CY | TW-SDAQ75CY | TW-SDAQ55CY |